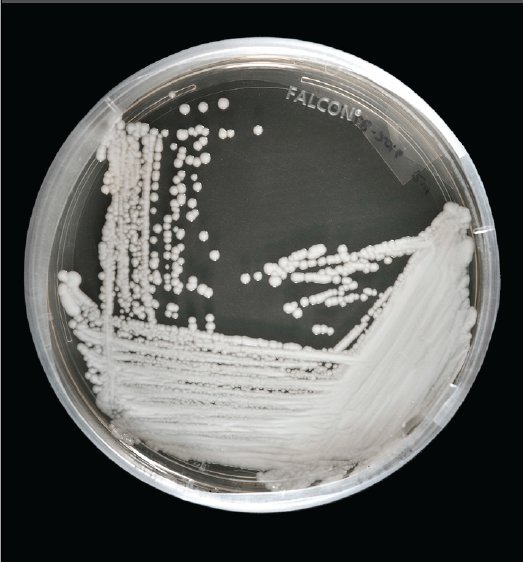
超级真菌如何应对,超级真菌最新官方消息

作者:徐英春1,2,肖盟1,2,黄晶晶1,2,陈新飞1,2,宁雅婷1,2,范欣2,杨洋1,2,冯佳佳3,林丽开3单位:1 中国医学科学院 北京协和医学院 北京协和医院检验科2 “侵袭性真菌病机制研究与精准诊断”北京市重点实验室3 武汉大学医院管理研究所基金项目:1 “艾滋病和病毒性肝炎等重大传染病防治”国家科技重大专项“病原细菌与突发急性真菌感染高通量快速检测与应急筛查技术研究”(2018ZX10712001)2 “精准医学研究”国家重点研发计划“罕见病临床队列研究”(2016YFC0901500)
2019年4月9日,《中国新闻周刊》刊发了题为“超级真菌被美国列为“紧急威胁”,中国已有18例确认感染”的文章(下简称“文章”),并被互联网广泛转载传播。
什么是”超级真菌”?”超级真菌”真的很可怕吗?为避免对该文章内容的过度解读,以致引起不必要的恐慌,我们特对该文章中的一些问题予以说明。
图片来源:
https://www.cdc.gov/fungal/candida-auris/candida-auris-qanda.html
一,所谓"超级真菌"的概念
首先,中文译名“超级真菌”是由“超级病原”(英文“Superbug”)的词义引申而来;准确的说, 国外研究报道中几乎没有使用过“超级真菌”(如“Super fungi”等)一词。
“超级病原”指对绝大部分抗菌药物泛耐药或全耐药的病原微生物,该词过去主要应用于细菌,包括目前被国内外广泛关注的碳青霉烯耐药肠杆菌科菌(carbapenem-resistant enterobacteriaceae,CRE)、耐甲氧西林金黄色葡萄球菌(methicillin-resistant Staphylococcus aureus,MRSA)、泛耐药的结核分枝杆菌(extensively drug-resistant tuberculosis,XDR-TB)等。
因此“超级病原”并非新的概念,早在2011年,为应对抗菌药物耐药,特别是“超级病原”带来的全球性威胁,世界卫生策划即提出了“今天不采取行动,明天就无药可用”的行动口号[1],并获得了包括我国政府在内的全球积极回应与行动支持[2]。
但在真菌领域罕有提及“超级病原”这一概念。目前侵袭性真菌疾病治疗的药物主要包括以下四类:
(I) 唑类药物:如氟康唑、伏立康唑、伊曲康唑、泊沙康唑;
(II) 棘白菌素类药物:如卡泊芬净、米卡芬净、阿尼芬净;
(III) 多烯类药物:如两性霉素B;
(IV) 嘧啶类药物:如5-氟胞嘧啶。
目前真正对抗真菌药物泛耐药或全耐药的病原全球罕见。
耳念珠菌之所以在国际上被冠以“超级病原”的称号,主要归因于以美国为主的地区所受到的威胁[3, 4]。
首先,美国首例耳念珠菌于2013年报道。但自2016年以来,监测发现耳念珠菌在纽约、新泽西、芝加哥等地的发病率快速升高,并出现大量院内感染的暴发案例[3, 4]。
其次,在美国发现的耳念珠菌,除对经典抗真菌药物氟康唑高度耐药外,半数以上的菌株对伏立康唑耐药,约1/3菌株对两性霉素B耐药。特别是对两性霉素B耐药在临床十分少见,使得耳念珠菌更受重视。此后,在包括英国、印度等多个国家和地区,也发现了高度耐药的耳念珠菌以及耳念珠菌引起院内感染暴发的案例[4-6],故使该种病原获得全球关注。
二,我国耳念珠菌的流行病学及耐药情况
我国现有的耳念珠菌病例报道以及流行病学监测数据显示,中国耳念珠菌在临床的发生发展情况与美国并不相同。但我们也需要重视以此次耳念珠菌“事件”为代表的临床真菌感染带来的医学挑战。
1. 整体看,耳念珠菌在国内的发生仍属个案
如上述文章中所提,目前中国大陆共报道耳念珠菌感染18例。根据对最新文献的检索,中国台湾地区也仅有1例耳念珠菌病例报道[7]。
中国大陆的病例源自3篇研究性文章[8-10],并无集中暴发的证据,同时在医疗机构环境中均未筛查到耳念珠菌[8, 9]。北京协和医院自2009年牵头我国首个多中心侵袭性真菌病流行病学与耐药性监测CHIF-NET项目,覆盖29个省级行政区的96家医院,在9个省建立了省级监测子网,覆盖机构133家;所有菌株均按规范收集至北京协和医院,使用分子测序或质谱方法进行准确鉴定。在至今收集的逾2万例真菌样本中,仅在2016年发现了1例耳念珠菌,发生率极低。
当然,目前美国及其他国家和地区关注的真菌院内感染问题,确实也需引起我们的重视。CHIF-NET监测数据显示,*平近**滑念珠菌在我国发生率排名第二、全国分离率约17%,但部分医院对该菌种的分离率显著高于平均水平。通过菌株同源性研究,我们有证据怀疑,这种真菌可能已在医疗机构中传播[11]。通过制定管理政策、提高人员意识、医院感控部门与医务人员及检验科通力合作的综合措施,病原的院内传播是可以预防和控制的。
2. 中国大陆分离的耳念珠菌耐药情况并不严重
上文已提到,“超级病原”主要指对临床可选抗菌药物泛耐药或全耐药的病原微生物。此次耳念珠菌在美国受到重视,原因之一是美国分离的菌株大部分对两性霉素B耐药[3],表型罕见,可能影响临床的经验性治疗效果。
截至目前,我国的报道显示,全国首例耳念珠菌分离株对所有抗真菌药物敏感,包括4种唑类药物、3种棘白菌素类药物、两性霉素B和5-氟胞嘧啶[10]。另一篇研究报道的两例耳念珠菌仅对氟康唑耐药,对其他药物敏感[8]。第3篇研究中的15例耳念珠菌菌株同样仅对氟康唑耐药,未发现对包括两性霉素B在内的其他抗菌药物耐药[9]。因此,称中国的耳念珠菌为“超级病原”甚至“超级真菌”并不适宜。
需要警惕的是,高度泛耐药病原真菌在我国确实存在!2009年,日本报道全球第1例耳念珠菌时,就提出耳念珠菌与另外一种致病真菌——希木龙念珠菌亲缘关系很近[12]。在我国CHIF-NET前5年的监测数据中,共发现31例希木龙念珠菌,发生率约0.3%;其中65%的希木龙念珠菌对四种唑类药物全耐药,超过50%与25%的菌株分别对两性霉素B和5-氟胞嘧啶耐药[13],耐药性远超我国的耳念珠菌。
此外,我国一些常见真菌的耐药性趋势变化已非常严峻。例如热带念珠菌在全国监测中的分离率与*平近**滑念珠菌相近(17%),但该菌种对氟康唑的耐药率以及不同唑类药物的交叉耐药率已从2010年的6%剧增到目前的超过21%,唑类不敏感率已超过40%[14],同时全国各地区耐药率均有显著上升。
真菌感染的流行病学与耐药性分布存在国家与地域性差异,我们必须持续加强国内的监测网络建设,以便精准、有效地发现我国存在的问题与挑战。
3. 耳念珠菌的致病性并无显著上升
“文章”中提到,“美国疾病控制与预防中心(CDC)已将耳念珠菌列入‘紧急威胁’名单。据其官网最新通报,全美感染病例已上升到587宗,近50%的感染者在90天内身亡”。准确地说,美国CDC在该篇报道所引用的原始文献[15]指出,在耳念珠菌引起的真菌血症中,30天死亡率达39%,90天死亡率达58%。事实上,这一死亡率在真菌引起的侵袭性感染中并无异常,侵袭性真菌病死率高、预后差已是临床共识。2013年意大利发布的AURORA研究显示,ICU中发生侵袭性真菌感染的死亡率为40.2%,其中由热带念珠菌感染的死亡率甚至高达77.8%[16]。侵袭性真菌感染多发生在危重症及免疫功能缺陷患者,死亡并非单纯由于真菌感染导致,而是多因素的临床结局。截止目前,我国尚未有耳念珠菌感染导致患者死亡的病例报道[9-10]。
综上所述,迄今为止我国耳念珠菌仍为临床偶发案例,且耐药性低,尚未发现异常致病性,因此无需受到美国等主要流行地区情况影响,过度解读目前形势。从国家健康发展战略层面看,应通过合理的顶层设计,持续性推进病原真菌的流行病学与耐药性监测工作,加强临床真菌实验室能力建设,加大对国内真正面临的真菌感染重大问题的研究支持,以便提供数据支撑、提升技术储备、完善管理策略,从防、诊、治全方位应对真菌感染对患者乃至社会带来的威胁。
参考文献
1 WHO. World Health Day – 7 April 2011. Antimicrobial resistance: no action today, no cure tomorrow. https://www.who.int/world-health-day/2011/en/. 2011.
2 国家卫生健康委员会. 国家卫生健康委办公厅关于持续做好抗菌药物临床应用管理工作的通知(国卫办医发〔2018〕9号). 2019.
3 CDC. U. Global Emergence of Invasive Infections Caused by the Multidrug-Resistant Yeast Candida auris. https://www.cdc.gov/fungal/diseases/candidiasis/candida-auris-alert.html. 2016.
4 CDC. U. Tracking Candida auris March 29, 2019: Case Count Updated as of February 28, 2019. https://www.cdc.gov/fungal/candida-auris/tracking-c-auris.html. 2019.
5 Clancy CJ, Nguyen MH. Emergence of Candida auris: An International Call to Arms. Clin Infect Dis. 2017; 64: 141-143.
6 Eyre DW, Sheppard AE, Madder H, Moir I, Moroney R, Quan TP, et al. A Candida auris Outbreak and Its Control in an Intensive Care Setting. N Engl J Med. 2018; 379: 1322-1331.
7 Tang HJ, Lai CC, Lai FJ, Li SY, Liang HY, Hsueh PR. Emergence of multidrug-resistant Candida auris in Taiwan. Int J Antimicrob Agents. 2019.
8 Chen Y, Zhao J, Han L, Qi L, Fan W, Liu J, et al. Emergency of fungemia cases caused by fluconazole-resistant Candida auris in Beijing, China. J Infect. 2018; 77: 561-571.
9 Tian S, Rong C, Nian H, Li F, Chu Y, Cheng S, et al. First cases and risk factors of super yeast Candida auris infection or colonization from Shenyang, China. Emerg Microbes Infect. 2018; 7: 128.
10 Wang X, Bing J, Zheng Q, Zhang F, Liu J, Yue H, et al. The first isolate of Candida auris in China: clinical and biological aspects. Emerg Microbes Infect. 2018; 7: 93.
11 Wang H, Zhang L, Kudinha T, Kong F, Ma XJ, Chu YZ, et al. Investigation of an unrecognized large-scale outbreak of Candida parapsilosis sensu stricto fungaemia in a tertiary-care hospital in China. Sci Rep. 2016; 6: 27099.
12 Satoh K, Makimura K, Hasumi Y, Nishiyama Y, Uchida K, Yamaguchi H. Candida auris sp. nov., a novel ascomycetous yeast isolated from the external ear canal of an inpatient in a Japanese hospital. Microbiol Immunol. 2009; 53: 41-44.
13 Hou X, Xiao M, Chen SC, Wang H, Cheng JW, Chen XX, et al. Identification and Antifungal Susceptibility Profiles of Candida haemulonii Species Complex Clinical Isolates from a Multicenter Study in China. J Clin Microbiol. 2016; 54: 2676-2680.
14 Xiao M, Sun ZY, Kang M, Guo DW, Liao K, Chen SC, et al. Five-Year National Surveillance of Invasive Candidiasis: Species Distribution and Azole Susceptibility from the China Hospital Invasive Fungal Surveillance Net (CHIF-NET) Study. J Clin Microbiol. 2018; 56.
15 Adams E, Quinn M, Tsay S, Poirot E, Chaturvedi S, Southwick K, et al. Candida auris in Healthcare Facilities, New York, USA, 2013-2017. Emerg Infect Dis. 2018; 24: 1816-1824.
16 Montagna MT, Caggiano G, Lovero G, De Giglio O, Coretti C, Cuna T, et al. Epidemiology of invasive fungal infections in the intensive care unit: results of a multicenter Italian survey (AURORA Project). Infection. 2013; 41: 645-653.
第一作者简介:

徐英春
研究员,博士生导师/博士后研究生导师。北京协和医院检验科主任、临床生物标本管理中心主任、北京协和医学院临床检验诊断学系主任。
主要研究方向:临床微生物感染病原学诊断及分子流行病学研究。
主要兼职包括:国家卫计委抗菌药物临床应用与细菌耐药评价专家委员会委员兼办公室主任、国家卫计委合理用药专家委员会全国细菌耐药监测网质量管理中心负责人、中国医学装备协会检验医学分会会长、中国医师协会检验医师分会常委、全球华人临床微生物感染学会(GCACMID)理事长、 欧洲临床微生物感染疾病学会(ESCMID)华人药敏试验委员会(ChiCAST)主任委员。
通信作者简介:

林丽开
毕业于复旦大学上海医学院。
现任武汉大学中南医院/武汉大学第二临床医学院教授,武汉大学医院管理研究所常务副所长,中国研究型医院杂志常务副总编辑。
从事图书及杂志编辑出版选题的循证评价研究、药物循证评价、医院管理研究、e-CRO课题设计、临床试验方案设计与优化、临床试验交叉学科论证。
国家卫健委抗菌药物临床应用与细菌耐药评价专家委员会委员,中国初级卫生保健基金会合理用药公益基金管委会副主任,中国医疗保健国际交流促进会循证医学分会常务委员,中国研究型医院学会感染性疾病循证与转化专业委员会常务委员兼秘书长,欧洲临床微生物和感染病学药敏委员会/华人抗菌药物敏感性试验委员会常务委员。